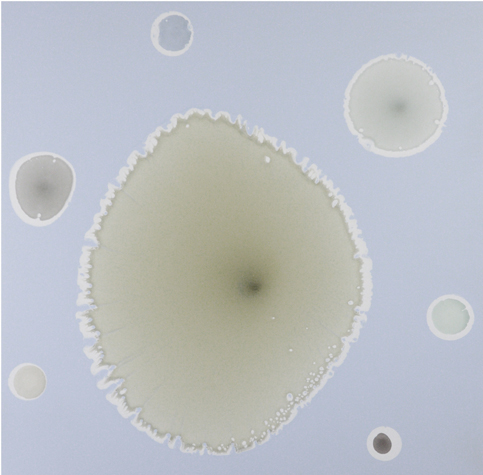
Jeff Leonard, BK10-11 Image

Artist CV
About
Born: Huntington Beach, CA
Currently lives and works in New York City
Artist Statement
My paintings are an exploration of the natural world, a place to search and discover new ways of seeing the world. In nature and in abstract painting there are elements that have rules as to how the elements fit together. Finding the rules and playing with them or trying to bend or break them is where the work starts. The elements of my paintings come from working with the materials to find out how it best creates space, forms, lines and color along with weight, gravity, movement and time.
Painting to me is like any kind of inventing, and just like other fields, to create something new is the ultimate goal. It is absorbing the history and growing or contributing to it. There is the combination of personal growth and the collective growth that moves the field along.
Leonard’s work is found in numerous public and private collections internationally including Deutsch Bank and Neiman Marcus.